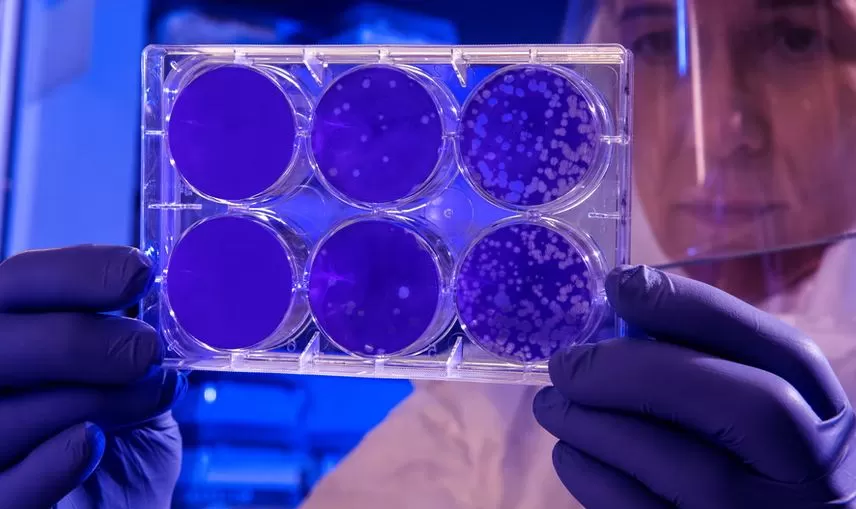
Viral Disease-Fighting Peptides

Viral infectious illnesses have led to millions of fatalities over time and have caused a substantial universal healthcare load. Enormous attempts have been undertaken by the scientific community, health professionals, and government agencies to diagnose, manage, and avoid viral illness. However, the intricate life cycle and fast genetic alterations of viruses necessitate the continual discovery of innovative medications with good effectiveness and safety profiles. Peptides give a hopeful outlook as a weapon to counteract the propagation and re-emergence of viral infection. The influenza virus, chronic hepatitis B, AIDS, severe acute respiratory syndrome, and coronavirus illness are all included in this article, which gives a worldwide perspective. The existing and prospective peptide-based treatments, vaccines, and diagnostics for each disease are described.
A virus’ life cycle includes five phases: adhesion to the target cell, fusion/cell entrance, multiplication within the host cell, assembly, and exit from the host cell. This way is how viruses spread: attaching to and replicating inside the host cell. Many antiviral medicines have been produced to target host cell receptors and/or phases of the viral lifecycle. These antiviral medicines may be split into six types: nucleoside and non-nucleoside inhibitors, integrase inhibitors, protease inhibitors, fusion inhibitors, and coreceptor antagonists. Even while existing medications have been demonstrated to reduce viral infection-related morbidity and death, the high genetic variation in the viral genome allows viruses to swiftly adapt and acquire treatment sensitivity. Because of this, it’s more important than ever to find and create new compounds, such as peptide-based medicines.
There are two types of peptides: natural and synthesized. A thorough literature analysis has shown natural peptides’ antiviral and immune-suppressant properties, including antimicrobial peptides (AMP). Hormones, neurotransmitters, and immunomodulators are all instances of organic peptides. Conversely, synthetic peptides are de novo peptides that are imagined by rational designs or found through the assistance of in vitro peptides research technologies such as phage and mRNA display. Both natural and synthetic peptides may comprise proteinogenic and non-proteinogenic amino acids as building blocks, altering the pharmacokinetic characteristics and increasing their effectiveness and safety profiles.
Natural or synthesized peptides have received tremendous interest in various uses as medicines, vaccines, and diagnostic markers. Peptides as therapies may integrate the benefits of tiny and big molecules due to their strong selectivity and capability to target difficult-to-reach sites. Peptide optimization such as multimerization and fusion to immunostimulatory adjuvants may be employed to further increase the immune reaction. Aside from that, peptides are used in a wide range of diagnostic tests to identify infectious disorders. Peptide-based diagnostic reagents are frequently utilized owing to their specificity, safety, applicability, and versatility.
Acquired immunodeficiency syndrome
Acquired Immunodeficiency Syndrome (AIDS) is caused by the human immunodeficiency virus (HIV). A weakened immune system leaves a person more susceptible to infection from other pathogens. The viral envelope (Env) protein is a vital driver of the infectious binding and fusion to the target cells and comprises two primary non-covalently linked glycoproteins, surface component gp120 and transmembrane gp41. These glycoproteins cover the nucleocapsid holding viral RNA and reverse transcriptase. The attachment of viral gp120 to the CD4 receptor reveals its attachment site to the chemokine coreceptor. Various chemokine receptors are activated based on the type of cell.
Currently, the primary antiviral medicines are small molecules, and just a handful are protein, peptide, or oligonucleotide-based therapeutics. Enfuvirtide, a 36 residue long peptide intended to replicate the C-terminal heptad repeat (CHR) of the helical region of gp41, was licensed by the FDA in 2003.
The initial line of defense against HIV infection is a few naturally occurring peptides. AMPs from bacteria, plants, animals, and humans have been widely investigated for their anti-HIV properties, and several have been evaluated as promising microbicide candidates. Microbicides are a prophylactic strategy used to inhibit the spread of HIV via sexual activity in females. As discussed previously, retrocyclins are natural θ-defensins generated by primates. As microbicides, studies have revealed that retrocyclins bind to both HIV-1 and host cell glycoproteins to block HIV entrance. The only human cathelicidin-derived AMP, LL-37, has also demonstrated anti-HIV efficacy. Three peptides, LL-37 and its two pieces LL13−37 and LL17−32, inhibit HIV-1 protease with poor activity with no reports of harmful consequences.
Throughout over 30 years of work, there has been no viable vaccine to avoid Hiv transmission and development. Most vaccines that have been produced have failed to generate a beneficial immune reaction towards Hiv disease in clinical trials. Engendering neutralizing antibodies using gp120 as an immunogen is less than optimal for creating HIV vaccines.
Conclusion
Infectious illnesses are an ongoing worldwide health problem with a significant impact on morbidity and death. The COVID-19 epidemic is the most current instance that has sparked significant worldwide attempts to speed therapeutic, vaccine, and diagnostic research. Increasing microbial resistance and low antiviral medication selectivity and effectiveness need the development of new molecules to combat these problems.
According to much research, peptide-based antiviral treatments and vaccines are in early development, and their use in the detection of viral infections is being explored. Peptide-based treatments have significant prospects as a revolutionary strategy owing to their excellent specificity, effectiveness, and safety. Nevertheless, the limited in vivo half-lives produced by proteolysis and renal clearance restricts the utility of naturally and synthetically generated peptides. The inclusion of D-amino acid in peptide chains has been found to boost peptide strength and proteolytic durability. The tiny size of peptides leads to renal drainage; consequently, fatty moieties are inserted to add to their size and enhance the half-life of peptides. In the future, HIV medications may benefit from peptide-based treatments that use extended-release dosage and eliminate the need for daily dosing. Nanoparticle attachment of peptides has been found to increase their solubility and potency and transport the targeted cell.
Researchers believe peptide-based vaccinations have promise for stimulating an immune reaction. A few peptide-based vaccines have shown remarkable promise in clinical tests. Allergies and autoimmune reactions may be avoided in peptide vaccines by using minimum microbial components instead of complete organisms or proteins. However, poor immunogenicity might be a limiting issue for peptide-based vaccines and may need the introduction of adjuvants. Lastly, peptides have been employed in novel techniques, such as biosensors, to diagnose viral infections. Peptides may assist in fighting a variety of viral infections, as we’ve shown in this article. If any of the information presented above is of interest to you, you can find peptides for sale online, for research purposes only.